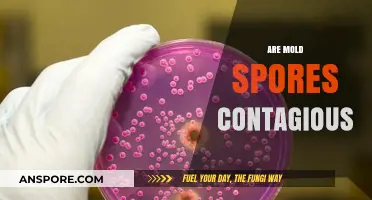
Are Mold Spores Contagious? Understanding Risks and Prevention Tips

Milky spores, scientifically known as *Paenibacillus popilliae*, are a natural bacterium used as a biological control agent against Japanese beetle grubs. While they are derived from organic sources and are not synthetic, the term organic in gardening or agriculture typically refers to compliance with specific certification standards, such as those set by the USDA. Milky spores are generally considered a safe and environmentally friendly option for pest control, but whether they qualify as organic depends on the context and the specific regulations governing their use. In most cases, they are approved for use in organic farming practices due to their natural origin and minimal environmental impact.
Explore related products
What You'll Learn
- Milky Spore Definition: Milky spores are a natural bacteria used to control Japanese beetle grubs in lawns
- Organic Certification: Milky spores are approved for use in organic gardening and farming practices
- Application Methods: Apply milky spores to soil as a powder or mixed with water
- Environmental Impact: Milky spores are safe for pets, humans, and beneficial insects, with no chemical residue
- Effectiveness Over Time: One application can provide grub control for up to 20 years

Milky Spore Definition: Milky spores are a natural bacteria used to control Japanese beetle grubs in lawns
Milky spores, scientifically known as *Paenibacillus popilliae*, are a biological control agent that targets Japanese beetle grubs, the larvae responsible for damaging lawns by feeding on grassroots. Unlike chemical pesticides, milky spores are a naturally occurring bacterium that infects and eliminates grubs without harming beneficial soil organisms, pets, or humans. This makes them an organic solution for lawn care, aligning with eco-friendly gardening practices.
To apply milky spores effectively, follow these steps: first, test your lawn for grub activity by cutting a square foot of turf and inspecting the soil for white, C-shaped larvae. If grubs are present, apply the spores at a rate of 1 to 2 teaspoons per 100 square feet, evenly distributing them across the affected area. Water the lawn lightly after application to activate the spores. Reapply every 2 to 3 weeks during late summer or early fall when grubs are actively feeding. Patience is key, as it may take 2 to 3 years for the spores to establish and significantly reduce grub populations.
One of the standout advantages of milky spores is their longevity. Once established in the soil, they can remain active for up to 20 years, providing continuous protection against Japanese beetle grubs. This contrasts sharply with chemical treatments, which often require annual applications and can disrupt soil ecosystems. However, milky spores are specific to Japanese beetle grubs and will not control other lawn pests, so proper identification of the problem is crucial before application.
For homeowners seeking an organic, long-term solution to grub infestations, milky spores offer a sustainable alternative to synthetic pesticides. They are safe for use around children, pets, and wildlife, making them ideal for residential lawns and gardens. While the initial cost may be higher than chemical treatments, the long-term benefits—both environmental and practical—make milky spores a worthwhile investment for maintaining a healthy, grub-free lawn.
Understanding Mould Spores: How They Spread and Thrive in Your Home
You may want to see also

Organic Certification: Milky spores are approved for use in organic gardening and farming practices
Milky spores, a natural bacteria-based product, have gained recognition as a powerful tool in the organic gardener's arsenal. This biological pesticide, derived from the bacterium *Bacillus popilliae*, specifically targets the larvae of Japanese beetles, a common garden pest. The beauty of milky spores lies in their organic certification, making them an eco-friendly and safe alternative to chemical pesticides.
The Organic Advantage:
Organic certification is a rigorous process, ensuring that products meet strict standards for sustainability and environmental safety. Milky spores' approval for organic use is significant, as it provides gardeners and farmers with an effective pest management solution without compromising their organic principles. This certification guarantees that the product is free from synthetic chemicals, making it safe for use around children, pets, and beneficial insects.
Application and Effectiveness:
To utilize milky spores, gardeners should apply the product to their lawns or garden beds during the late summer or early fall when Japanese beetle larvae are actively feeding. The recommended dosage is typically 1-2 pounds per 1,000 square feet, ensuring thorough coverage. Once applied, the spores germinate and produce toxins that specifically target the beetle larvae, leaving other organisms unharmed. This targeted approach is a key advantage over broad-spectrum chemical pesticides.
Long-Term Benefits:
The impact of milky spores extends beyond immediate pest control. As an organic solution, it contributes to the overall health of the garden ecosystem. Unlike chemical pesticides, which can have detrimental effects on soil health and beneficial organisms, milky spores promote a balanced environment. Over time, repeated applications can lead to a significant reduction in Japanese beetle populations, creating a more sustainable and resilient garden.
A Comparative Perspective:
In contrast to traditional chemical pesticides, milky spores offer a unique, species-specific approach. While chemical treatments may provide quick results, they often come with environmental and health risks. Milky spores, on the other hand, provide a long-term, preventative solution. This organic method aligns with the principles of integrated pest management, encouraging a harmonious relationship between pest control and environmental preservation. By choosing milky spores, gardeners and farmers actively contribute to a more sustainable and ecologically conscious approach to agriculture.
Are Black Mold Spores Black? Unveiling the Truth Behind the Color
You may want to see also

Application Methods: Apply milky spores to soil as a powder or mixed with water
Milky spores, a biological control agent, are often applied to soil to combat Japanese beetle grubs. The application method—whether as a powder or mixed with water—significantly influences their effectiveness. Powdered milky spores are typically broadcast directly onto the soil surface, where they adhere to the roots and are ingested by grubs. This method is straightforward and ideal for large areas, as it allows for even distribution using a spreader. For smaller gardens or targeted spots, mixing milky spores with water creates a slurry that can be poured or sprayed, ensuring deeper penetration into the soil. Both methods rely on the spores’ ability to persist in the soil for years, making them a long-term solution for grub control.
When applying milky spores as a powder, timing is crucial. The soil should be moist, and the grubs must be actively feeding near the surface, typically in late summer or early fall. Use a rate of 1 to 5 pounds per 1,000 square feet, depending on the infestation level. After application, water the area lightly to activate the spores without washing them away. This method is cost-effective and minimizes labor, but it requires dry conditions to prevent clumping. For best results, avoid applying during windy weather to ensure the spores remain in the target area.
Mixing milky spores with water offers greater precision, especially in areas with uneven terrain or heavy thatch. Combine 1 tablespoon of spores with 1 gallon of water per 100 square feet, stirring thoroughly to create a uniform suspension. Apply the slurry using a watering can or sprayer, focusing on areas where grubs are most active, such as near plant roots. This method is particularly useful for established lawns or gardens where even coverage is challenging. However, it requires more effort and may be less practical for large-scale applications.
While both application methods are effective, their success depends on environmental conditions. Milky spores thrive in soils with a pH between 6.0 and 8.0 and temperatures above 60°F, as these conditions encourage grub activity and spore germination. Regardless of the method chosen, repeated applications over 2–3 years may be necessary to establish a robust spore population. Always follow product instructions, as over-application can waste resources without improving efficacy.
In conclusion, the choice between powder and water-mixed applications hinges on the specific needs of your lawn or garden. Powdered spores offer simplicity and broad coverage, while the slurry method provides targeted control. Both are organic, safe for pets and wildlife, and contribute to a sustainable approach to pest management. By understanding these methods and their nuances, you can effectively harness the power of milky spores to protect your soil from Japanese beetle grubs.
Where to Legally Obtain Psilocybin Spores for Research and Cultivation
You may want to see also
Explore related products
$18.27 $19.97

Environmental Impact: Milky spores are safe for pets, humans, and beneficial insects, with no chemical residue
Milky spores, a natural bacteria-based product, offer a unique solution for grub control in lawns and gardens without the environmental and health risks associated with chemical pesticides. Derived from *Bacillus popilliae*, these spores target Japanese beetle grubs specifically, leaving beneficial insects, pets, and humans unharmed. Unlike synthetic chemicals that can persist in the soil and water, milky spores degrade naturally, leaving no harmful residue. This makes them an ideal choice for eco-conscious homeowners and gardeners seeking sustainable pest management.
For those considering application, the process is straightforward but requires patience. Milky spores are most effective when applied in late summer or early fall, when grubs are actively feeding near the soil surface. The recommended dosage is typically 1 to 5 billion spores per acre, depending on infestation severity. Simply mix the spores with water or sand and distribute evenly across the affected area. Reapplication may be necessary every 1–3 years, as the spores multiply over time, establishing long-term control. Always follow product instructions for best results.
One of the most compelling advantages of milky spores is their safety profile. Unlike chemical pesticides, which can pose risks to children, pets, and pollinators, milky spores are non-toxic and pose no threat to non-target organisms. This makes them particularly appealing for households with young children or pets who frequently play in treated areas. Additionally, beneficial insects like bees, butterflies, and earthworms remain unaffected, ensuring the health of your garden ecosystem. For organic gardeners, milky spores are a certified organic option, aligning with sustainable practices.
Comparatively, chemical pesticides often leave behind residues that can contaminate soil, water, and food chains. Milky spores, however, work by infecting and eliminating grubs naturally, with no lingering environmental impact. This distinction is critical for those concerned about long-term ecological health. While the initial cost of milky spores may be higher than chemical alternatives, their lasting effectiveness and minimal environmental footprint make them a cost-effective investment over time.
In practical terms, integrating milky spores into your lawn care routine is a proactive step toward reducing chemical dependency. Start by testing a small area to gauge effectiveness, then expand as needed. Combine their use with other organic practices, such as proper watering and soil aeration, to maximize results. For pet owners, the peace of mind that comes with knowing your lawn is safe for furry friends is invaluable. Milky spores exemplify how innovation in natural solutions can harmonize pest control with environmental stewardship.
Endospore-Forming Organisms: Dangerous Pathogens or Harmless Survivors?
You may want to see also

Effectiveness Over Time: One application can provide grub control for up to 20 years
Milky spores, a biological pesticide derived from the bacterium *Bacillus popilliae*, offer a remarkable solution for long-term grub control. One application of this organic treatment can provide protection for up to 20 years, making it a standout option for environmentally conscious gardeners and landscapers. This longevity stems from the spores’ ability to multiply in the soil as they infect and eliminate Japanese beetle grubs, creating a self-sustaining defense mechanism. Unlike chemical pesticides that degrade quickly, milky spores persist, ensuring continuous protection without repeated applications.
To maximize the 20-year effectiveness, proper application is critical. The recommended dosage is 1 to 2 teaspoons of milky spore powder per 10 square feet of lawn, applied evenly during late summer or early fall when grubs are actively feeding. Water the treated area thoroughly to activate the spores and help them penetrate the soil. For larger areas, a spreader can ensure even distribution. It’s essential to apply the product when soil temperatures are between 60°F and 70°F, as this is when grubs are most susceptible. Avoid treating waterlogged or frozen soil, as it can hinder spore activity.
While the 20-year claim is impressive, real-world effectiveness can vary based on environmental factors. Heavy clay soils or areas with poor drainage may reduce spore mobility, limiting their spread. Additionally, new grub infestations from neighboring untreated areas can reintroduce the problem. To mitigate this, consider coordinating treatment with neighbors or reapplying milky spores in high-risk zones after 5 to 10 years. Regular monitoring for grub activity, such as patchy or spongy turf, can help identify the need for additional intervention.
The long-term efficacy of milky spores makes them a cost-effective and labor-saving solution compared to annual chemical treatments. Over two decades, the initial investment in milky spores pays off by eliminating the need for repeated purchases and applications of synthetic pesticides. This not only reduces financial burden but also minimizes environmental impact, as milky spores are non-toxic to humans, pets, and beneficial insects. For those seeking sustainable lawn care, this once-and-done approach aligns with organic principles while delivering lasting results.
Practical tips can further enhance the longevity of milky spore treatments. Maintain a healthy lawn through proper watering, mowing, and aeration to discourage grub infestations. Avoid over-fertilizing, as excessive nitrogen can attract beetles that lay eggs. If grubs are detected despite treatment, spot-treat with nematodes or other organic methods to address localized issues without compromising the overall milky spore population. By combining milky spores with good lawn management practices, you can ensure two decades of grub-free turf with minimal effort.
Understanding Mold Spores: Size in Microns and Health Implications
You may want to see also
Frequently asked questions
Yes, milky spores are considered organic as they are a natural bacterium (Bacillus popilliae) used to control Japanese beetle grubs in lawns.
Absolutely, milky spores are approved for use in organic gardening and farming because they are a biological pest control method.
No, milky spores are not chemically treated or synthetic; they are a naturally occurring bacterium found in soil.
No, milky spores are safe for beneficial insects, plants, pets, and humans, making them an environmentally friendly option.
Yes, milky spores are often certified by organic organizations, such as the USDA Organic program, as they meet organic standards for pest control.